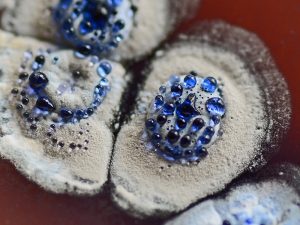

The focus of the group is on genetic engineering approaches applied to fermentation processes of microorganisms of industrial relevance, aimed at producing secondary metabolites (antibiotics), bioactive peptides and proteins.
Staff and contacts
-
-
- Prof. Flavia Marinelli (full professor)
- Dr. Francesca Berini (researcher)
- Dr. Elisa Binda (technician)
- Dr. Oleksandr Yushchuk (postdoctoral fellow)
- Dr. Ana Simatovic (postdoctoral fellow)
- Dr. Melissa Bisaccia (PhD student)
- Dr. Luca Mellere (PhD student)
- Dr. Letizia Bartolone (postgraduate fellow)
- Dr. Lorenzo Tonin (PhD student)
- Dr. Davide Malacarne (postgraduate fellow)
- Dr. Luciano Gastaldo (guest)
-
Find us: Campus Bizzozero; Via Dunant, 3; 21100 Varese; yellow and purple floor
Keywords: Microbial biodiversity, Fermentation, Antibiotics, Glycopeptides, Antibiotic resistance, Actinomycetes, Heterologous expression, Metagenomics, Bioinsecticides
ERC sectors: LS9_1 Applied biotechnology (including transgenic organisms, applied genetics and genomics, biosensors, bioreactors, microbiology, and bioactive compounds). LS9_2 Applied bioengineering, synthetic biology, chemical biology, nanobiotechnology, metabolic engineering, protein and glyco-engineering, tissue engineering, biocatalysis, biomimetics. LS6_7 Biological basis of prevention and treatment of infection (e.g. infection natural cycle, reservoirs, vectors, vaccines, antimicrobials)
Our collaborations: Department of Food, Environmental and Nutritional Sciences, and Department of Biosciences, University of Milan, Milan Italy; BioC-CheM Solutions Srl Gerenzano, Varese Italy; Department of Biological and Environmental Sciences and Technologies, Salento University, Lecce Italy; Enea, Casaccia, Rome Italy; Coastal marine environment institute, CNR, Messina Italy; Water Research Institute, CNR-IRSA, Verbania Italy; Zurich University of Applied Sciences, Wädenswil Switzerland; Department of Biotechnology, University of Chemistry and Technology, Prague Czech Republic; Department of Molecular Microbiology, John Innes Centre, Norwich UK; Microbial Genomics and Biotechnology Center for Biotechnology (CeBiTec), Universität Bielefeld, Bielefeld Germany; Division of Physical Chemistry, Ruđer Bošković Institute, Zagreb Croatia; MIGAL Galilee Research Institute, Kiryat-Shmona Israel; Departamento de Química Orgánica y Farmacéutica Universidad Complutense de Madrid, Madrid Spain; Department of Genetics and Biotechnology, Ivan Franko National University of Lviv, Lviv Ukraine; Instituto de Biotecnología y Biología Molecular (IBBM) Facultad de Ciencias Exactas, La Plata, Buenos Aires Argentina; Technische Universität Berlin, Berlin Germany.